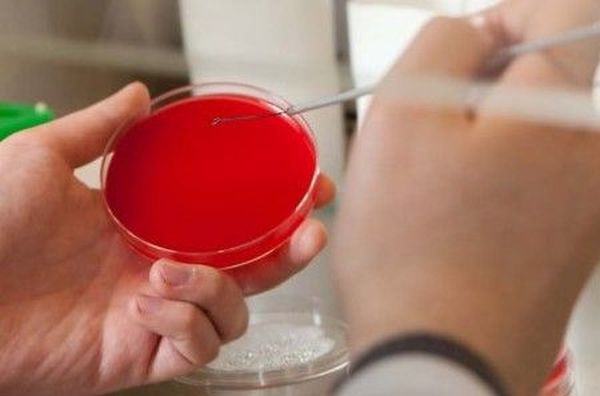

Современное общество пропагандирует безопасный секс. Но, несмотря на это, не уменьшилось распространение скрытых инфекций, передающихся половым путем. Более того, передаются они настолько молниеносно, что прогнозы медиков порой приводят в ужас. Каждый третий человек, живущий половой жизнью, подвергается заболеваниям передающимся половым путем (ЗППП). К одним из таких распространенных и чаще всего протекающих в скрытой форме заболеваний относится ureaplasma species.
Что представляет собой уреаплазма?
Уреаплазма специес представляет собой инфекцию, которая передается половым путем. Возбудителями данного заболевания выступают внутриклеточные паразиты, которые являются чем-то средним между вирусами и бактериями. Они мельче крупных вирусов и не имеют клеточной оболочки.
Название возбудителя исходит от способности бактерии расщеплять мочу. По сути, без мочевины ее существование фактически невозможно.
Данные внутриклеточные паразиты еще до недавних пор считались условно-патогенными организмами. Это означало, что они могли находиться в слизистой оболочке мочеполовой системы человека и ничем не проявлять себя до какого-то определенного момента. Обнаружение их ни к чему не обязывало ни врача, ни пациента. Но в настоящее время эти микробы перевели в разряд патогенных и их наличие требует определенных действий.
Около 70% населения, живущего половой жизнью, является бессимптомными носителями инфекции.
Пути передачи инфекции
Заразиться уреаплазмой можно несколькими путями. Основным и чаще всего встречающимся является половой контакт. Стоит заметить, что инфицирование может произойти и во время орального секса.
Существуют и другие способы заражения:
- внутриутробный способ заражения матерью ребенка, представляющий собой большую опасность и имеющий самые тяжелые и порой непредсказуемые последствия;
- инфицирование непосредственно во время рождения малыша, при его прохождении по родовым каналам зараженной матери;
- при пересадке внутренних органов;
- во время переливания крови, что происходит нечасто.
Кроме этих способов передачи данного заболевания, отмечается тесный бытовой контакт. Инфицирование в таких случаях возможно нечасто, но оно все же имеет место.
Существует немало факторов, которые способствуют распространению инфекции:
- Незащищенный половой акт;
- Частая смена половых партнеров, которая отрицательно сказывается на биосфере слизистых оболочек половых органов;
- Раннее начало половой жизни. В таких случаях организму трудно вступать в борьбу с чужой флорой;
- Лечение некоторыми антибиотиками и гормонами;
- Ослабление иммунной системы в результате перенесенной простуды, авитаминоза, нервного потрясения, злоупотребления алкоголем;
- Травмы на слизистых оболочках половых органов;
- Отклонения от норм в микрофлоре женского влагалища;
- Отклонение от норм гигиены, применение синтетического нижнего белья и плотно прилегающей одежды.
ДНК ureaplasma species обнаружено: что это значит?
Пришедший из лаборатории ответ, в котором указано, что обнаружена уреаплазма должен насторожить пациента. Бланк со словом «обнаружено» обозначает, что у человека имеют место фрагменты ДНК болезнетворных микроорганизмов.
Только врач может определить стадию и тяжесть заболевания, назначить соответствующую терапию.
Клинические проявления, которые должны послужить поводом для сдачи анализов:
- уретрит;
- простатит;
- воспалительные процессы в малом тазу;
- бесплодие;
- патологии в предыдущих беременностях;
- проблемы с вынашиванием детей.
Отличительные черты уреаплазмы
У данного заболевания существует определенная характеристика:
- Недуг может проходить в острой и хронической форме.
- Течение болезни чаще всего проходит без симптомов, что для подобных возбудителей довольно частое явление.
- Клинические проявления инфекции проявляются в зависимости от органа, пораженного микроорганизмом.
- Выявление заражения в наши дни возможно даже в случае его бессимптомного течения.
- При хроническом течении заболевания необходима комплексная терапия.
- Для некоторых женщин эти микроорганизмы считаются нормой в микрофлоре влагалища, поэтому данный вопрос лучше рассмотреть вместе в квалифицированным специалистом, который сможет решить, лечить ли недуг или оставить все как есть.
Симптоматика уреаплазмы
У этого заболевания самые различные клинические проявления. Со времени заражения до первых признаков болезни иногда проходит от 28 дней до нескольких месяцев. Скрытое течение недуга может длиться долго, что чревато заражением инфекцией других половых партнеров, ведь несмотря на бессимптомное течение инфицирование имеет место и человек является носителем уреаплазмы.
Только через месяц после инфицирования могут начать проявляться первые симптомы.
Женский организм устроен несколько иначе, чем мужской, поэтому именно женщинам чаще всего свойственно бессимптомное течение заболевания. В медицинской практике наблюдались случаи, когда заболевание у женщин длилось около 10 лет. Причем все это время они даже не подозревали о наличии недуга.
Уреаплазма специес у женщин
Инфицирование представительниц слабого пола сопровождается следующими симптомами:
- мочеиспускание становится частым и болезненным;
- постоянно преследует чувство переполненного мочевого пузыря и затруднение процесса мочеиспускания;
- наблюдается зуд в районе наружных половых органов и в мочеиспускательном канале;
- влагалищные выделения становятся слизистыми или жидкими;
- овуляция сопровождается кровянистой слизью;
- отмечаются боли внизу живота, которые особенно усиливаются при мочеиспускании или половом акте;
- снижается либидо;
- наблюдается боль, локализующаяся в районе печени;
- появляются высыпания на кожных покровах;
- беспокоят частые простудные заболевания;
- диагностируется эрозия шейки матки с сопровождающими ее гнойными выделениями;
- женщине трудно забеременеть.
Уреаплазма специес у мужчин
У мужчин инфицирование проявляется несколько иначе:
- самым распространенным признаком заболевания у мужского пола считается наличие не гонококкового уретрита;
- после пробуждения наблюдаются мутные выделения в незначительном количестве;
- мочеиспускание сопровождается резями и болями;
- в области гениталий наблюдается зуд и жжение;
- появляются выделения из уретры, которые через время снова исчезают;
- воспаляются яички и их придатки;
- снижается половое влечение;
- нарушается репродуктивная функция;
- пораженная микроорганизмом предстательная железа проявляет себя симптомами простатита.
Все эти симптомы характерны при остром течении заболевания. При отсутствии лечения симптоматика постепенно стихает. Но это не говорит о том, что болезнь отступила и уреаплазмы исчезли из организма.
Недуг просто перешел в хроническую фазу, что чревато ремиссиями, сменяющимися периодическими обострениями в зависимости от многих факторов, влияющих на снижение иммунитета.
Чем опасна уреаплазма и каковы ее последствия?
Стоит заметить, что женский уреаплазмоз наблюдается гораздо чаще, чем мужской. Такое случается по причине влагалищной колонизации бактерий не вызывающей симптоматики.
Инфицирование женского организма данными бактериями нередко приводит к разным заболеваниям. Наиболее распространенными из них являются такие недуги:
- кольпит, проявляющийся воспалением слизистой оболочки во влагалище;
- цервицит, для которого характерны воспалительные процессы в шейке матки;
- неоплазия шейки матки, характеризующаяся наличием нетипичных клеток и появлением злокачественных опухолевых новообразований;
- уретральный синдром, симптомом которого является частое, сопровождающееся болями мочеиспускание.
Уреаплазмоз опасен как для мужчин, так и для представительниц прекрасного пола. Его самым серьезным и необратимым последствием является бесплодие. Продолжительные воспалительные процессы слизистых оболочек чреваты поражением маточных труб и внутренних слоев матки. Такие патологии приводят к тому, что женщине становится довольно сложно зачать ребенка. Заражение же во время беременности в частых случаях заканчивается самопроизвольным выкидышем на раннем сроке или преждевременными родами.
На мужские сперматозоиды уреплазмы тоже действуют отрицательно. Они затормаживают их двигательную активность или вовсе их убивают.
Всех отрицательных последствий можно избежать, если после того, как при подозрении на ureaplasma species анализы показали положительный результат и ДНК паразитов все-таки в них были обнаружены, человек вовремя обращается за медицинской помощью и приступает к незамедлительной терапии. Важно не допустить перехода заболевания в хроническую форму, симптоматика которой становится малозаметной.
Диагностика
Диагностику уреаплазмы врач обычно начинает с внешнего осмотра гениталий. У мужчин заметить отклонения можно, пальпируя мошонку и ректально исследуя простату. После чего у пациента берется мазок из уретры, моча и семенная жидкость. Пока производятся анализы мужчине рекомендуется пройти УЗИ предстательной железы и мошонки, с помощью которого диагноз опровергается или, наоборот, подтверждается.
Для определения недуга у женщины ее влагалище и шейка матки тоже осматривается врачом. Кроме этого, применяется пальпация яичников и гинекологическое обследование. Для полного прояснения картины также необходимо УЗИ малого таза.
Из лабораторных исследований заболевания чаще всего применяются следующие:
- ПЦР, представляющая собой полимерно-цепную реакцию. Для исследования необходима заборная жидкость пациента, в которой определяется наличие ДНК паразита. Такой метод хорош тем, что заболевание можно выявить в настоящем времени. В качестве заборного материала используется мазок из влагалища и уретры женщины, собранная утром моча и сперма мужчины.
- Бактериологическое исследование. Этот метод помогает определить, к какому типу возбудителя относится данный паразит и выбрать антибиотик, к которому он проявляет свою чувствительность. Этот способ определения инфекции занимает много времени. В общей сложности на него уходит не менее 7 дней. Поэтому в частых случаях прибегают к более быстрому методу диагностирования с помощью ПЦР.
- Есть еще один способ, благодаря которому можно определить инфицирование уреаплазмой – иммуноферментальный анализ (ИФА). Он не гарантирует высокой точности диагностики, поэтому применяется крайне редко.
Надо ли лечить заболевание?
Не всегда присутствие уреаплазм в организме пациента говорит о том, что нужно срочно приступать к лечению. Существуют определенные пределы нормы содержания возбудителя. К примеру, в 1 мл исследуемой жидкости пациента 10 4 уреаплазм считается нормальным. Повышение концентрации микроорганизмов говорит о том, что необходимо приступить к лечению.
Что касается результатов анализов на уреаплазмоз у беременных женщин, то в этом случае показатели несколько другие. Антибактериальная терапия женщинам в интересном положении требуется, если концентрация микроорганизмов доходит до 10 3 , иначе трудно будет избежать тяжелых воспалительных процессов, угрозы жизни и здоровью будущего малыша.
Лечение
Если врач после всех методов исследований пришел к выводу, что необходимо незамедлительно начать лечение, стоит придерживаться следующих рекомендаций:
- Следует полностью отказаться от половых контактов обоим партнерам;
- Важно следовать определенной диете, включающей в себя отказ от острой, соленой пищи и алкогольных напитков;
- Через 14 дней по окончании терапии в обязательном порядке нужно пройти повторное обследование и лишь после подтверждения полного излечения можно вернуться к привычной повседневной жизни.
Лечение производится в несколько этапов.
Антибиотикотерапия
Данный метод считается самым основным при избавлении от уреаплазмы. Для этого используются такие препараты:
- Микролиды – Азитромицин, Свумамед;
- Фторхинолоны – Цифран, Супракс.
Иммуномодуляторная терапия
С помощью нее повышаются защитные функции организма. Отлично зарекомендовали себя в этом плане следующие препараты:
- Иммуномакс;
- Амиксин;
- Ликопид.
Противопротозойная и противогрибковая терапия
В профилактических целях врачи назначают медикаменты, помогающие избежать кандидоза:
Кроме этого, назначается прием ферментов и витаминов. В лечении уреаплазмы специес у беременных женщин вместо антибиотиков внутривенно вводятся иммуноглобулины и проводятся сеансы озонотерапии.
Чтобы полностью излечиться от данной инфекции в среднем потребуется около 60 дней. Более сильное поражение организма, перешедшее в хроническую форму, требует длительного лечения, которое затягивается иногда на полгода.
Важно не заниматься самолечением, а положиться на компетентность и знания своего лечащего врача. Это поможет полностью избавиться от недуга и избежать возможных рецидивов.
Профилактика
Предупредить уреаплазмоз можно, стоит лишь придерживаться элементарных правил:
- В процессе полового акта использовать презервативы.
- В случае незащищенного секса желательно обработать половые органы антисептиками.
- Следовать основным правилам личной гигиены половых органов.
- Периодически обследоваться на ЗППП.
- Не запускать хронические заболевания мочеполовой системы.
- Вести здоровый образ жизни.
- Заниматься укреплением иммунной системы.
Медицинская статистика свидетельствует: последние несколько лет в бланках с результатами анализов пациентов все реже встречаются строки «уреаплазма норма» или «условный нормоценоз», а количество выявляемых заболеваний, вызванных условно-патогенными микроорганизмами, растет год от года.
Частота постановки диагноза «уреаплазменная инфекция» достигает 20% у относительно здоровых женщин. Уреаплазмы в мазке, взятом у дам из группы риска, обнаруживаются еще чаще — в 30% случаев от общего количества обследуемых.
Впечатляют и данные педиатров: каждый пятый ребенок инфицируется во время прохождения по родовым путям.
У мужчин выявляют уреаплазму уреалитикум в повышенных колич. значениях гораздо реже, чем у представительниц слабого пола. Раннее обнаружение возбудителей заболевания и правильное лечение гарантируют полное избавление от недуга.
О том, как распознать болезнь, какие показатели уреаплазмы у женщин считаются нормой, к чему может привести отсутствие адекватной терапии — в материале ниже.
Краткое описание болезни
Уреаплазма (или Ureaplasma spp) — представитель семейства Mycoplasmataceae, присутствующий в микробиоценозе слизистой половых органов и мочевыделительной системы большинства относительно здоровых женщин. Патоген не всегда провоцирует развитие недуга (уреаплазменной инфекции): естественным барьером для роста и развития колоний возбудителя является иммунитет. Снижение уровня последнего становится поводом к активному размножению внутриклеточного микроорганизма и, как следствие — возникновению болезни.
На сегодняшний день ученым известно более полутора десятков серотипов рассматриваемых инфекционных агентов. Наибольший интерес для медицинских светил представляют 2 группы патогенов:
- Т-960 (другое название микроорганизмов — уреаплазма Parvum), колонии которых располагаются преимущественно в тканях половых органов сильной половины человечества. Согласно некоторым исследованиям, у мужчин эта группа микроорганизмов вызывает воспалительные процессы в простате и уретре. Уреаплазма парвум у женщин выявляется на порядок реже.
- Ureaplasma urealyticum, чаще встречающаяся у представительниц слабого пола. По мнению врачей, микроб негативно влияет на развитие эмбриона во время беременности.
Схемы терапии заболеваний, вызванных этими патогенами, одинаковы.
Термин «уреаплазмоз» — более привычное название рассматриваемого заболевания — во врачебной практике не используется. При обнаружении в анализах больного превышения показателей нормы уреаплазмы и наличия дополнительных симптомов ставится диагноз «уреаплазменная инфекция».
Симптомы недуга
К прямым признакам болезни у женщин относятся:
- частое мочеиспускание, сопровождающееся резкими болевыми ощущениями, жжением;
- обильные выделения;
- зуд в промежности;
- боли в нижней части живота («тянущего» характера);
- снижение либидо;
- неприятные ощущения при половом сношении;
- кровяные включения в выделениях после сексуальных отношений;
- проблемы с наступлением беременности.
В медицинской литературе описаны случаи сопровождения недуга косвенными симптомами, в числе которых — сыпь на кожных покровах; нарушение работы печени, повышенная подверженность простудным заболеваниям.
Если инфицирование произошло при незащищенном оральном сексе, то признаками заболевания могут быть:
- налет на гландах;
- затрудненное глотание;
- боли при приеме пищи.
Следует знать, что уреаплазмоз может протекать без наличия ярко выраженных признаков. В этом случае женщина-носитель, не подозревающая о наличии заболевания, инфицирует партнера при незащищенном половом акте.
Симптомы недуга у мужчин:
- резь и боли при мочевыделении;
- снижение либидо;
- незначительные выделения;
- болезненные ощущения в мошонке, внизу живота;
- неприятные ощущения во время полового акта.
Уреаплазмоз у женщин, находящихся в положении, может передаться ребенку двумя путями: внутриутробно и в процессе родов.
Диагностирование
Заподозрить наличие у пациента описываемой инфекции и назначить дополнительные анализы может инфекционист или гинеколог, педиатр-неонатолог или уролог.
При отсутствии выраженных симптомов болезни показаниями к проведению специальных исследований является следующие моменты:
- Беспорядочная половая жизнь.
- Бесплодие.
- Наличие в гинекологическом анамнезе женщины внематочной или замершей беременности, невынашивания, патологий плода.
- Воспаления мочевыделительной системы.
Если супружеская пара приняла решение зачать ребенка, то анализы на соответствие содержания уреаплазм в тканях и жидких средах организма показателям нормы придется сдать и мужчине, и женщине.
Потребуется пройти дополнительные обследования и перед плановыми оперативными манипуляциями.
Современная медицина располагает несколькими способами определения наличия (отсутствия) колоний патогенов в организме человека.
Бактериологический посев
Рассматриваемый культуральный метод исследования проводится чаще остальных. Материалом для проведения бакпосева является мазок, который берется из мочеполового канала либо из канала шейки матки.
Для культивирования патогенов образец помещается в особую емкость с питательной средой — чашку Петри. Если уреаплазмы в мазке присутствуют, то они будут образовывать колонии.
Для получения результатов, свидетельствующих о наличии или отсутствии вредоносных микроорганизмов в анализе, потребуется от 4 до 8 дней.
Читайте также по теме
Дополнительно с определением присутствия микроорганизмов бакпосев позволяет выявить их чувствительность к антибиотикам.
Иммуноферментный анализ
Проведение ИФА (или серологического анализа) позволяет выявить наличие в организме пациента антител к инфекции. Исследуемый образец — кровь больного; длительность диагностирования материала — 24 часа. Многие специалисты считают результаты ИФА неточными, поскольку при сбоях в иммунитете антитила к уреаплазме могут не вырабатываться.
Большой процент вероятности постановки неправильного диагноза и объясняет непопулярность рассматриваемого метода. Его результаты, как правило, расцениваются в качестве ориентира для дальнейшего исследования состояния организма больного.
При отсутствии заболевания в графе бланка с указанием титра (количества антител) будет добавлено слово «норма». Поскольку специалисты разных медучреждений считают нормой у женщин разную степень наличия уреаплазм (подробнее об этом ниже), то цифра при прохождении обследования в нескольких больницах может быть неодинаковой.
Полимеразную цепную реакцию относят к высокоточным методам количественного определения отклонений от показателей нормы Ureaplasma spp., проводимым в кратчайший период времени (за 4 часа). Материал для исследования — выделения из половых органов, урина.
Недостатком ПЦР считается невозможность выявления активности патогена. Кроме того, анализ может быть:
- ложноотрицательным (при проведении антибиотикотерапии незадолго до сдачи образца);
- ложноположительным (в случае загрязнения исследуемого материала).
Метод ПЦР позволяет определить, какой тип уреаплазмы СПП является возбудителем заболевания — Parvum или Urealyticum.
Для уточнения диагноза лечащий врач может назначить комплексное проведение исследований (например, ПЦР и бакпосев). Такой подход позволит исключить и человеческий фактор, влияющий на результат диагностики (неправильную транспортировку материалов, некачественную подготовку пациента к сдаче анализа).
Правила подготовки к забору анализов
В целях получения максимально точных результатов анализов пациенту следует соблюдать несколько важных рекомендаций:
- Ужин накануне назначенной даты забора материалов должен быть диетическим.
- В день сдачи крови завтракать либо пить кофе (чай) нельзя.
- Время сбора урины на анализ — утреннее первое мочеиспускание.
- Перед сдачей мазка необходимо воздерживаться от сексуальных связей в течение 48 часов. При менструации, как правило, соскоб и мазок не берут. За 72 часа до посещения гинеколога не применяют вагинальные таблетки, контрацептивы-суппозитории и противозачаточные средства в форме линимента; за 8-10 часов — не проводят гигиену половых органов.
Чтобы результат мазка или соскоба содержали достоверную информацию, пациентка должна сдавать анализ в середине менструального цикла.
Какая норма уреаплазмы у здоровых женщин?
Однозначного ответа на вопрос, вынесенный в заголовок данного раздела, не даст ни один врач. Связано это с отсутствием точных исследований микроорганизма и вызываемого им заболевания.
В клинической практике принято считать показателями нормы уреаплазмы значение 10*4 (или 10 в 4-й степени на один миллилитр исследуемых материалов).
Вышеуказанный показатель называют усредненным, поскольку:
- ряд специалистов придерживается мнения о предельной черте нормы уровня уреаплазмы СПП в 10*5;
- некоторые исследователи считают максимальное количество патогенов в анализах — не более 10 3 КОЕ/мл.
Но, несмотря на вышеуказанные расхождения, специалисты единогласно утверждают: уреаплазма уреалитикум норма — это значения менее 10*4. Повышение показателя свидетельствует о наличии активных патогенов.
Подробнее о значениях, указанных в бланках результатов наиболее популярных типов диагностики, в таблице ниже.
Методика
Уреаплазма уреалитикум, показатели (в КОЕ/мл) нормальное значение
у мужчин и женщин
предельный показатель нормы уреаплазмы для пациентов результат, требующий проведения терапии ПЦР в норме10*3
допустимо10*4
10*4-10*5 10*5 и выше Бакпосев
Расшифровку полученных анализов должен проводить только лечащий врач, самостоятельно делать заключение о наличии превышения нормы уреаплазмы и применять антибиотикотерапию без консультации доктора запрещено. При высоких показателях специалист назначает дополнительные исследования и комплексное лечение.
Если значение, указанное в бланке результатов исследований, ниже 10 3 КОЕ/мл, то применять антибактериальную терапию не требуется. Следует помнить: наличие уреаплазм в небольших количествах в человеческом организме считается допустимыми нормами.
Немного истории
Почему концентрация 10 4 КОЕ/мл считается количественной нормой? Ответить на вопрос поможет нижеследующая историческая справка.
Своими корнями значение уреаплазма уреалитикум нормы уходит в далекий 1956 год, когда исследователь Э.Касс разделил пациентов с бессимптомным протеканием болезни на 2 типа — нуждающихся в применении терапии, и тех, кому лечение не показано. Именно уровень 10*5 стал пограничным.
С мнением именитого ученого согласились его последователи. И лишь спустя пару десятков лет специалисты обнаружили, что недуг выявляется и у женщин, показатель уреаплазмы у которых находится в норме (или даже понижен на 1/3).
Как ни странно, но число исследований, проведенных в мире для определения нормальных показателей уреаплазмы уреалитикум, можно пересчитать по пальцам.
- анализ возникновения инфекций мочевыделительной системы у мужчин, обследование которых на наличие Ureaplasma urealyticum показывало значения от 10*4;
- теория Хоровитца об увеличении риска возникновения у родивших женщин такого недуга, как эндометрит, при высокой концентрации Ureaplasma spp (более 10*5) в их организме;
- изыскания 1988 г. о влиянии уреаплазмы при беременности на преждевременное родоразрешение.
Именно поэтому количественные показатели нормы Ureaplasma spp. закрепились на уровне 10 4 КОЕ/мл.
Нормы условно-патогенной микрофлоры у женщин, ожидающих ребенка
О негативном влиянии на развитие плода уреаплазменной инфекции, обнаруженной у дамы в положении, свидетельствуют многочисленные статистические данные.
Ureaplasma urealyticum, не купированная в период до зачатия ребенка, может стать фактором, который способен вызвать:
- гипоксию плода;
- нарушение маточно-плацентарного кровотока;
- замирание беременности;
- выкидыш;
- патологию развития эмбриона;
- малый вес у новорожденного.
Именно поэтому все гинекологи рекомендуют обследоваться на наличие заболевания задолго до планируемого зачатия.
Если беременность наступила, а при плановом обследовании на ИППП у женщины был диагностирован уреаплазмоз, пресекать недуг потребуется путем задействования антибиотикотерапии, что крайне опасно для плода.
Следует знать, что у многих дам, ожидающих ребенка, обнаруживается активный патоген. Норма уреаплазмы при беременности — 10 3 КОЕ/мл. При такой концентрации инфекционных агентов врач может посоветовать восстановить микрофлору половых органов путем использования местных средств (суппозиториев, вагинальных таблеток и пилюль).
При высоком значении (от 10*3) следует говорить о развитии воспалительных процессов, купировать которые могут только антибиотики в совокупности с иммуностимуляторами.
Перед процедурой ЭКО наличие показателей уреаплазмы, превышающих допустимые нормы (выше10 3 ), свидетельствует о необходимости назначения женщине терапии, нормализующей состояние микрофлоры и повышающей иммунитет.
Строго запрещено пытаться самостоятельно снизить увеличенные показатели нормы уреаплазмы в организме, проводя лечение антибактериальными препаратами без консультации акушера-гинеколога!
Уреаплазмоз — не приговор для ребенка и будущей матери. При тщательном соблюдении врачебных рекомендаций в 97% случаев уровень уреаплазмы возвращается к норме.
Терапия патологических отклонений
Схемы лечения уреаплазменной инфекции современной медициной проработаны досконально.
Нужно помнить, что в ряде случаев специалисты медклиник посоветуют пройти повторный курс терапии для полного излечения.
Уреаплазмоз в запущенной форме купируется очень сложно; при полном отсутствии признаков заболевания возможны случаи рецидива, спровоцированные понижением уровня иммунитета, беременностью и рядом других факторов.
Каждая стадия болезни пресекается путем задействования различных типов медицинских товаров, а именно:
- острое протекание недуга потребует использования антибактериальных медикаментов;
- хроническая форма — комплексного применения лекарственных средств местного, общего типов действия и иммуномодуляторов;
- подострая купируется сочетанием общих и местных средств.
Антибактериальная терапия
Включение в схемы лечения антибиотиков возможно лишь после определения резистентности патогенов к медицинским товарам антимикробного действия. На данный момент одного медикамента, губительно воздействующего на указанные группы уреаплазм у женщин и мужчин, нет, поэтому врач порекомендует одновременное задействование нескольких препаратов.
В числе антибиотиков, применяемых в борьбе с уреаплазменной инфекцией и выравнивающих норму уреаплазмы до требуемых значений:
- лекарства группы тетрациклинов (Доксициклин);
- представители ряда фторхинолов (Моксифлоксацин);
- медикаменты-макролиды (Кларитромицин).
С целью снижения негативного влияния антибиотиков на организм дополнительно будут назначены антимикозные медицинские товары (свечи, таблетки, суппозитории).
Решать, какие препараты следует принимать и сколько курсов лечения нужно пройти, может только врач.
При расчете дозировки специалист обязательно учитывает состояние больного, наличие в его анамнезе индивидуальной непереносимости лекарственных средств, тяжесть течения недуга.
Иммунотерапия и общее укрепление организма
В целях укрепления иммунитета пациенту будет предложено принимать иммуностимуляторы (например, Циклоферон).
Восстановление организма проводится при помощи:
- ферментов (в частности, Вобензима);
- биостимуляторов;
- антиоксидантов и адаптогенов (в числе последних — препарат Эстифан).
По окончании лечения специалисты медклиник рекомендуют пациентам пройти повторные анализы для определения нормы уреаплазмы.
Часто схема дополнительных проверок включает до 4 исследований, проводимых с интервалом в 3 месяца. Такая методика применяется в отношении пациентов группы риска:
- женщин, часто меняющих половых партнеров;
- дам со слабым иммунитетом;
- представительниц прекрасного пола, имеющих в анамнезе инфекционные заболевания органов малого таза.
Дальнейшая сдача биологических материалов на определение нормы уреаплазмы назначается ежегодно.
Игнорировать рекомендации врачей не следует: хронические формы уреаплазменной инфекции чреваты развитием серьезных осложнений, в числе которых — восходящий пиелонефрит, аднексит и вторичное бесплодие.
Уреаплазма специес – грамотрицательные бактерии, которые являются представителями Mycoplasmataceae. Они объединяют сразу два семейства – уреаплазма уреалитикум и павум.
Данные бактерии обитают в органах мочеполовой системы, крайне редко могут размножаться в легочных тканях. Некоторые врачи считают – если микроорганизмы не провоцируют негативную симптоматику, то проводить лечение не нужно.
Что же делать? Для начала советуем почитать статью с главного института паразитологии Российской Федерации. В данной статье раскрывается метод, с помощью которого можно почистить свой организм от паразитов, без вреда для организма. Читать статью >>>
Пути заражения
Если при сдаче анализов в них обнаружена днк микроорганизма не нужно паниковать. В таких случаях люди часто задаются вопросом, как и где можно было заразиться уреаплазмой специес.
- Незащищенный половой контакт (анальный, оральный, вагинальный) – самый распространенный способ заражения. Основным носителем бактерии являются женщины, у которых проявляется выраженная симптоматика болезни и имеется более двух половых партнеров в течение года. Мужчины зачастую становятся временными носителями, при этом они могут инфицировать своих половых партнеров.
- Уреаплазма может попасть в организм при пересадке органов. Довольно редко инфицирование может произойти при гемотрансфузии.
- Бактерия проникает в матку через плаценту, провоцируя воспаление плодного пузыря, внутриутробное заражение плода. Если лечение при беременности не проводится, есть вероятность, что у ребенка будет развиваться врожденная пневмония.
- Также заражение ребенка происходит во время прохождения по родовым путям.
Заражение невозможно бытовым способом, а также при посещении общественных мест, например, сауны, туалета, бассейна, открытого водоема.
Факторы риска
Заболевание проявляется при определенных условиях. К факторам риска относятся:
- беспорядочные половые связи;
- аутоиммунные заболевания;
- венерические болезни;
- хронические патологии мочеполовой системы;
- чрезмерное использование растворов Хлоргексидина, Мирамистина;
- длительный прием антибиотиков (которые не эффективны против уреаплазмы), кортикостероидов, оральных контрацептивов;
- переохлаждения, стресс;
- беременность;
- хронический простатит;
- повреждение слизистой уретры;
- высокий уровень рН влагалища.
Симптомы заболевания
Что говорят врачи о лечении паразитов
Доктор медицинских наук, профессор Герман Шаевич Гандельман
Стаж работы: более 30 лет.
Занимаюсь обнаружением и лечением паразитов уже много лет. С уверенностью могу сказать, что паразитами заражены практически все. Просто большинство из них крайне трудно обнаружимы. Они могут быть где угодно — в крови, кишечнике, легких, сердце, мозге.
Паразиты в буквальном смысле пожирают вас изнутри, заодно отравляя организм. В итоге, появляются многочисленные проблемы со здоровьем, сокращающие жизнь на 15-25 лет.
Основная ошибка — затягивание! Чем раньше начать выводить паразитов, тем лучше. Если же говорить о лекарствах, то тут всё проблематично. На сегодняшний день существует только один действительно эффективный антипаразитный комплекс, это TOXIMIN. Он уничтожает и выметает из организма всех известных паразитов — от головного мозга и сердца до печени и кишечника. На такое не способен больше ни один из существующих сегодня препаратов.
В рамках Федеральной программы, при подаче заявки до 10 июня. (включительно) каждый житель РФ и СНГ может получить одну упаковку TOXIMIN БЕСПЛАТНО!
В подавляющем большинстве, симптоматика болезни отсутствует. Обследование может выявить нарушения мочеполовой системы.
Уреаплазма специес у мужчин
Зачастую обнаружить заболевание можно лишь после сдачи анализов. Однако, если для микроорганизма создаются благоприятные условия, он провоцирует развитие определенных заболеваний.
| Провоцируемая патология | Описание |
| Уретрит | Протекает вяло и склонен к самоизлечению. Может перерасти в хроническую форму. В утреннее время из полового члена могут наблюдаться гнойно-слизистые выделения. |
Половой контакт и мочеиспускание сопровождается болями, возникает зуд в области уретры. Также возникает ноющая боль внизу живота и чувство полного мочевого пузыря после похода в туалет.
Эпидидимит Представляет собой острую боль в районе яичка. Сопровождается:
- повышением температуры;
- болями в суставах, мышцах;
- при ходьбе возникает боль в мошонке;
- отек мошонки.
Сексуально-связные артриты Зачастую поражают коленные суставы, лодыжки. Проявляется в виде:
- боли, отека этих участков;
- трудностей при ходьбе;
- плохого сгибания этих суставов.
Бесплодие Уреаплазма может паразитировать на шейке сперматазоида, приводя к снижению его подвижности, саморазрушению сперматазодиных клеток.
Также эта бактерия выделяет фермент, ухудшающий текучесть спермы. Может развиваться эректильная дисфункция.
Уреаплазма специес у женщин
Бактерия, так же как и у мужчин может вовсе не проявлять себя и это норма. Но иногда, она может поселиться в матке, что чревато серьезными последствиями.
Если для уреаплазмы создаются благоприятные условия, у женщины будут развиваться заболевания гинекологического, урологического характера.
| Провоцируемая болезнь | Описание |
| Бактериальный вагиноз | Развивается зуд и жжение в районе вульвы. Из влагалища наблюдаются обильные пенистые выделения с характерным запахом и цветом. |
| Цистит | Женщина страдает от: |
- частых мочеиспусканий, которые сопровождаются малым выделением мочи;
- болей, жжения при мочеиспускании;
- чувства полного мочевого пузыря;
- болей в животе;
- общей слабости;
Возможно, изменение цвета мочи с появлениями примесей крови.
Цервицит Развитие тупой боли над лобком. Из влагалища выделяется слизь с гноем. Половой акт сопровождается неприятными ощущениями.
Поскольку заболевание может не проявлять себя, обнаружить микроорганизм поможет лишь расшифровка анализов.
Уреаплазма специес требует лечения только в тех случаях, если наблюдается ухудшение состояния человека, он сталкивается с осложнениями в виде вторичных болезней. Зная причины заражения, можно снизить вероятность инфицирования, придерживаясь профилактических норм.
Победить паразитов можно!
Toximin® — средство от паразитов для детей и взрослых!
- Отпускается без рецепта врача;
- Можно использовать в домашних условиях;
- Очищает от паразитов за 1 курс;
- Благодаря дубильным веществам оздоравливает и защищает от паразитов печень, сердце, легкие, желудок, кожу;
- Избавляет от гниения в кишечнике, обезвреживает яйца паразитов благодаря моллекуле F.
Сертифицированное, рекомендуемое врачами-гельминтологами средство для избавления от паразитов в домашних условиях. Имеет приятный вкус, который понравится детям. Состоит исключительно из лекарственных растений, собранных в экологически чистых местах.
Сейчас действует скидка. Препарат можно получить бесплатно.
Здравствуйте, читатели сайта о паразитах Noparasites.ru. Меня зовут Александр Лигнум. Я автор данного сайта. Мне 23 года, я студент 5 курса Кемеровского государственного медицинского института. Специализация «Паразитолог». Консультация по телефону: +7 (495) 152-58-95. Подробнее об авторе>>
Лучшие истории наших читателей
Тема: Во всех бедах виноваты паразиты!
От кого: Людмила С. (ludmil64@ya.ru)
Кому: Администрации Noparasites.ru
Последние несколько лет чувствовала себя очень плохо. Постоянная усталость, бессонница, какая-то апатия, лень, частые головные боли. С пищеварением тоже были проблемы, утром неприятный запах изо рта.
А вот и моя история
Все это начало скапливаться и я поняла, что двигаюсь в каком-то не том направлении. Стала вести здоровый образ жизни, правильно питаться, но на мое самочувствие это не повлияло. Врачи тоже ничего толком сказать не могли. Вроде как все в норме, но я то чувствую, что мой организм не здоров.
Потом я пошла в одну дорогую клинику и сдала все анализы, так вот в одном из анализов у меня обнаружили паразитов. Это были не обычные глисты, а какой-то определенный вид, которым, по словам врачей, заражен практически каждый, в большей или меньшей степени. Вывести из организма их практически невозможно. Я пропила курс противопаразитных лекарств, которые назначили мне в той клинике, но результата почти не было.
Через пару недель я наткнулась на одну статью в интернете. Эта статья буквально изменила мою жизнь. Сделала все, как там написано и уже через несколько дней я почувствовала значительные улучшения в своем организме. Стала высыпаться намного быстрее, появилась та энергия, которая была в молодости. Голова больше не болит, появилась ясность в сознании, мозг стал работать намного лучше. Пищеварение наладилось, несмотря на то, что питаюсь я сейчас как попало. Сдала анализы и убедилась в том, что больше во мне никто не живет!
Кто хочет почистить свой организм от паразитов, причем неважно, какие виды этих тварей в вас живут — прочитайте эту статью, уверена на 100% вам поможет! Перейти к статье>>>